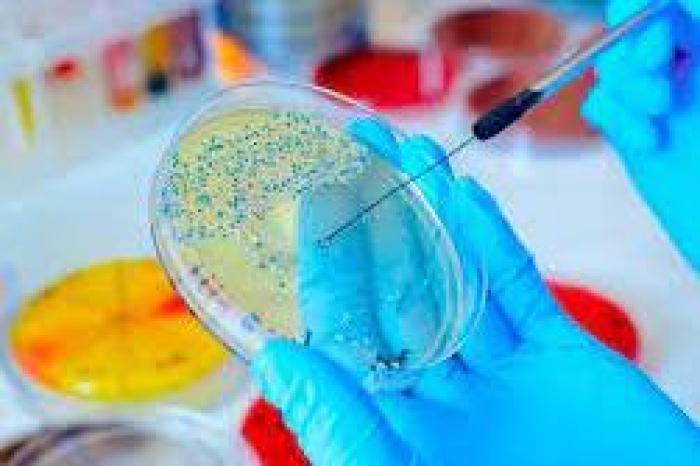
course-premium

Máster en Microbiología Clínica - DIPLOMA LEGITIMADO POR NOTARIO EUROPEO -
Master
Online

¿Necesitas un coach de formación?
Te ayudará a comparar y elegir el mejor curso para ti y a financiar tu matrícula en cómodos plazos.
¡Dedícate a lo que te apasiona!
-
Tipología
Master
-
Metodología
Online
-
Idiomas
Castellano
-
Horas lectivas
600h
-
Duración
1 Año
-
Campus online
Sí
-
Tutor personal
Sí
-
Clases virtuales
Sí
El Máster en Microbiología Clínica ofrece una formación que abarca diversas áreas cruciales para profesionales en el ámbito de la microbiología clínica. Desde el estudio de microorganismos y enfermedades infecciosas hasta técnicas de diagnóstico, tratamiento de infecciones, control de bioseguridad y las implicaciones éticas y sociales de la microbiología clínica.
Este programa, disponible en el catálogo de cursos de Emagister, es impartido por Esneca Medical and Science School. Con una duración de un año, se lleva a cabo en modalidad online, proporcionando acceso al campus virtual, clases virtuales y la asistencia de tutores personalizados.
Aborda conceptos fundamentales como la anatomía y fisiología de bacterias, hongos y virus, medios para el cultivo de microorganismos, diagnóstico microbiológico, métodos de identificación microbiana, enfermedades infecciosas y sus tratamientos, parasitología clínica, y el impacto de la microbiología clínica en la sociedad. Al culminar satisfactoriamente el programa y superar las pruebas de evaluación, este logro se ve coronado con la obtención de un diploma que certifica el "Máster en Microbiología Clínica", respaldado por la institución Esneca Medical & Science.
Si deseas formarte en esta área, no dudes en comunicarte con los asesores de Emagister para obtener más información y comenzar tu trayectoria en la microbiología clínica.
Información importante
Documentos
- EMS145.pdf
Precio a usuarios Emagister:
A tener en cuenta
Permite conocer los conceptos y técnicas básicas de microbiología clínica, los medios de cultivo y técnicas de análisis bacteriológico, las proteobacterias, las bacterias gram positivas, las espiroquetas y microorganismos eucarióticos, la identificación de bacterias y hongos de interés clínico, los antibióticos y los fármacos antifúngicos. Además, al final de cada unidad didáctica el alumno/a encontrará ejercicios de autoevaluación que le permitirán hacer un seguimiento del curso de forma autónoma y reforzar aquellos aspectos que considere oportunos, basándose en los resultados obtenidos a partir de la realización de los ejercicios.
El Programa está especialmente diseñado para aquellas personas que estén interesadas en adquirir conocimientos sobre Microbiología Clínica y que quieran asegurarse un recorrido ascendente en esta área, con una especial elevación y consolidación de competencias.
Una vez finalizados los estudios y superadas las pruebas de evaluación, el alumno recibirá un diploma que certifica el “MÁSTER EN MICROBIOLOGÍA CLÍNICA ”, del ESNECA MEDICAL & SCIENCE, avalada por nuestra condición de socios de la CECAP, máxima institución española en formación y de calidad. Los diplomas, además, llevan el sello de Notario Europeo, que da fe de la validez, contenidos y autenticidad del título a nivel nacional e internacional. El contenido del curso se encuentra orientado hacia la adquisición de formación teórica complementaria. Este curso no conduce a la obtención de una titulación oficial.
El alumno recibirá acceso a un curso inicial donde encontrará información sobre la metodología de aprendizaje, la titulación que recibirá, el funcionamiento del Campus Virtual, qué hacer una vez el alumno haya finalizado e información sobre Grupo Esneca Formación. Además, el alumno dispondrá de un servicio de clases en directo.
Opiniones
Logros de este Centro
Todos los cursos están actualizados
La valoración media es superior a 3,7
Más de 50 opiniones en los últimos 12 meses
Este centro lleva 2 años en Emagister.
Materias
- Microbiología clinica
- Tipos de microorganismos
- Enfermedades bacterianas
- Diagnostico de enfermedades
- Tratamiento de enfermedades
Temario
MICROBIOLOGÍA CLÍNICA
MÓDULO 1. MICROORGANISMOS Y ENFERMEDADES INFECCIOSAS
- Unidad didáctica 1. Vida: definición y elementos
- Unidad didáctica 2. Concepto y tipos de microorganismos
- Unidad didáctica 3. Modos de transmisión de los microorganismos
- Unidad didáctica 4. Patogenicidad
MÓDULO 2. INTRODUCCIÓN A LA MICROBIOLOGÍA CLÍNICA
- Unidad didáctica 1. Conceptos y técnicas básicos
- Unidad didáctica 2. Historia de la microbiología clínica
MÓDULO 3. ANATOMÍA Y FISIOLOGÍA DE LAS BACTERIAS
- Unidad didáctica 1. Concepto de bacterias
- Unidad didáctica 2. Morfología de las bacterias y estructura bacteriana
- Unidad didáctica 3. Bacterias patógenas comunes
- Unidad didáctica 4. Enfermedades bacterianas y su tratamiento
MÓDULO 4. ANATOMÍA Y FISIOLOGÍA DE LOS HONGOS
- Unidad didáctica 1. Identificación y caracterización de hongos
- Unidad didáctica 2. Hongos patógenos comunes
- Unidad didáctica 3. Enfermedades micóticas y su tratamiento
MÓDULO 5. ANATOMÍA Y FISIOLOGÍA DE LOS VIRUS
- Unidad didáctica 1. Identificación y caracterización de virus
- Unidad didáctica 2. Virus patógenos comunes
- Unidad didáctica 3. Enfermedades virales y su tratamiento
MÓDULO 6. MEDIOS PARA EL CULTIVO DE MICROORGANISMOS
- Unidad didáctica 1. Componentes
- Unidad didáctica 2. Tipos de medios
- Unidad didáctica 3. Preparación de los medios
- Unidad didáctica 4. Técnicas de aislamiento y recuento de microorganismos
MÓDULO 7. DIAGNÓSTICO MICROBIOLÓGICO
- Unidad didáctica 1. Muestreo y recolección de material biológico
- Unidad didáctica 2. Preparación de las muestras
- Unidad didáctica 3. Técnicas de identificación
MÓDULO 8. MÉTODOS DE IDENTIFICACIÓN MICROBIANA
- Unidad didáctica 1. Métodos físicos
- Unidad didáctica 2. Métodos químicos
- Unidad didáctica 3. Métodos bioquímicos
- Unidad didáctica 4. Métodos genéticos
MÓDULO 9. ENFERMEDADES INFECCIOSAS Y SUS TRATAMIENTOS
- Unidad didáctica 1. Infecciones respiratorias
- Unidad didáctica 2. Infecciones gastrointestinales
- Unidad didáctica 3. Infecciones de la piel y tejidos blandos
- Unidad didáctica 4. Infecciones genitourinarias
- Unidad didáctica 5. Infecciones sistémicas
- Unidad didáctica 6. Infecciones posquirúrgicas
- Unidad didáctica 7. Infecciones en grupos de riesgo
MÓDULO 10. PARASITOLOGÍA CLÍNICA
- Unidad didáctica 1. Identificación y caracterización de parásitos
- Unidad didáctica 2. Parásitos patógenos comunes
- Unidad didáctica 3. Enfermedades parasitarias y su tratamiento
MÓDULO 11. ANTIBIÓTICOS Y RESISTENCIA A LOS ANTIBIÓTICOS
- Unidad didáctica 1. Características de los antibióticos
- Unidad didáctica 2. Mecanismos de acción
- Unidad didáctica 3. Clasificación
- Unidad didáctica 4. Resistencia antibiótica
MÓDULO 12. CONTROL DE INFECCIONES Y BIOSEGURIDAD
- Unidad didáctica 1. Medidas de prevención
- Unidad didáctica 2. Control de la transmisión
- Unidad didáctica 3. Prácticas de bioseguridad en el laboratorio
MÓDULO 13. MICROBIOLOGÍA CLÍNICA Y SU IMPACTO EN LA SOCIEDAD
- Unidad didáctica 1. Avances tecnológicos
- Unidad didáctica 2. Implicaciones éticas y sociales.
MÓDULO 14. INMUNOLOGÍA Y MICROBIOLOGÍA CLÍNICA
- Unidad didáctica 1. Sistema inmunológico
- Unidad didáctica 2. Terapias inmunológicas
MÓDULO 15. TENDENCIAS Y FUTURO DE LA MICROBIOLOGÍA CLÍNICA
- Unidad didáctica 1. Avances tecnológicos
- Unidad didáctica 2. Nuevas áreas de investigación
- Unidad didáctica 3. Desafíos y oportunidades.
¿Necesitas un coach de formación?
Te ayudará a comparar y elegir el mejor curso para ti y a financiar tu matrícula en cómodos plazos.
Máster en Microbiología Clínica - DIPLOMA LEGITIMADO POR NOTARIO EUROPEO -









